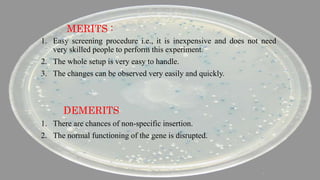
MERITS :
1. Easy screening procedure i.e., it is inexpensive and does not need
very skilled people to perform this experiment.
2. The whole setup is very easy to handle.
3. The changes can be observed very easily and quickly.
DEMERITS
1. There are chances of non-specific insertion.
2. The normal functioning of the gene is disrupted.
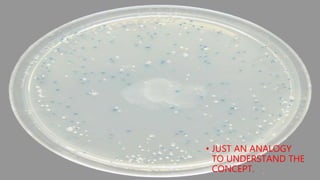
• JUST AN ANALOGY
TO UNDERSTAND THE
CONCEPT.
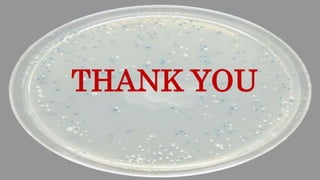
THANK YOU

Insertional inactivation is a technique used in genetic engineering where a fragment of foreign DNA inserts into the genome of a host cell. This insertion disrupts or inactivates an existing gene, such as one that confers antibiotic resistance. Screening methods rely on insertional inactivation to detect recombinant cells. For example, blue/white screening uses disruption of the lacZ gene to distinguish cells with and without recombinant DNA insertion.